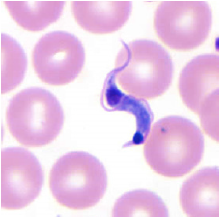
Enunciado 1007886-1

Foram encontradas 950 questões.
A norma NN 3.01 da CNEN, para mulheres grávidas ocupacionalmente expostas, afirma que as tarefas dessas mulheres devem ser controladas de maneira que, a partir da notificação da gravidez, seja improvável que o feto, durante o resto do período de gestação, receba dose efetiva superior a
Provas
A Recreação Terapêutica, considerando seus objetivos, associados às condições de longo período de internação a que os pacientes clínicos estão submetidos, pode favorecer momentos agradáveis que dirimiam os problemas e auxiliam no tratamento e cura. A recreação é uma atividade que, quando bem planejada, orientada e executada, se desenrola de maneira normal, tornando-se imprescindível e permanente para a vida do ser humano. A recreação terapêutica pode ser ministrada em qual das situações a seguir?
Provas
São consideradas técnicas passivas de desobstrução de vias áreas, EXCETO
Provas
Diante de um garoto de 6 anos que caiu do telhado, de uma altura de aproximadamente 5 metros, a equipe observa que a criança está pálida e não responsiva à estimulação. Qual seria a conduta inicial?
Provas
Um dos grandes problemas enfrentados pelos povos no mundo se refere ao sedentarismo. Associado a ele, a obesidade, as cardiopatias, a diabetes e tantas outras doenças aparecem com índices muito preocupantes, principalmente nas populações de jovens em idade escolar. A tecnologia parece agravar ainda mais esse quadro. Diante desse fato, quais esportes podem ajudar a combater o sedentarismo?
Provas
Assinale a alternativa com o nome do parasita encontrado na seguinte amostra de sangue.
Provas
Assinale a alternativa que apresenta o valor da dose de ataque das medicações usadas na Parada cardiorrespiratória (PCR).
Provas
A Classificação de Risco é um processo dinâmico de identificação dos pacientes que necessitam de tratamento imediato, de acordo com o potencial de risco, agravos à saúde ou grau de sofrimento e alguns requisitos são necessários e precisam ser avaliados e planejados para sua implantação. Considerando o exposto, assinale a alternativa correta.
Provas
Qual documento deve ser emitido pelo médico, a cada exame ocupacional realizado, de acordo com a NR 7, sendo que uma via fica arquivada na empresa e a outra é entregue ao trabalhador?
Provas
Um dos exames realizados na radiografia convencional com contraste é o Enema opaco ou Clister opaco. Esse procedimento visa estudar o
Provas
Caderno Container